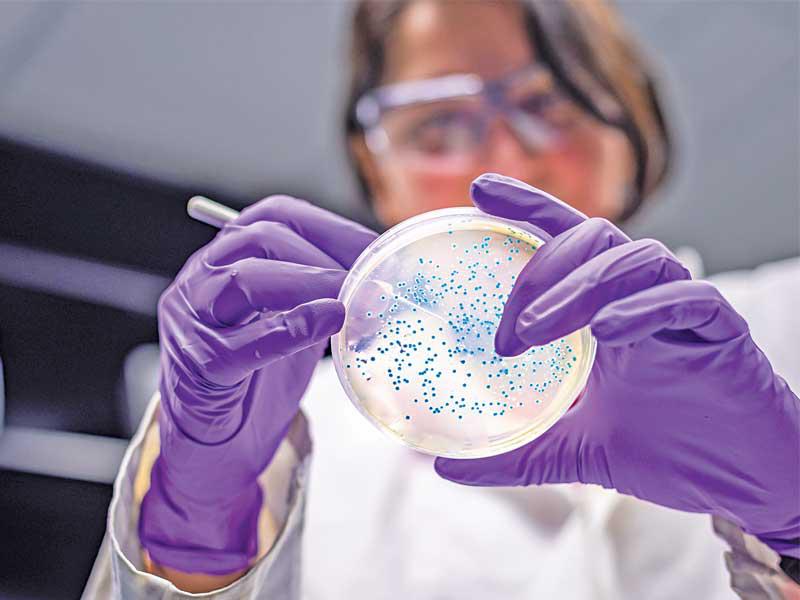

بكتيريا قاتلة تنتشر في مستشفيات أوروبا
خلصت دراسة أوروبية موسعة إلى أن البكتيريا المقاومة للمضادات الحيوية تنتشر في مستشفيات القارة وإسرائيل.وتستخدم عقاقير تسمى كاربابينيم عندما تخفق العقاقير الأخرى جميعاً في علاج العدوى.
وقال باحثون في معهد سانغر إن انتشار بكتيريا كلبسييلا نيمونيا "مقلق جداً"، وحذروا في دراستهم، التي نشرتها "بي بي سي" على موقعها الإلكتروني، أمس، من أنه يمكن لبعض الأنواع الأخرى من البكتيريا أن تصبح مقاومة للعقاقير أيضاً، بسبب الطريقة الفريدة التي تتكاثر بها،
وهي "بكتيريا تعيش بصورة طبيعية في الأمعاء دون أن تتسبب في أي متاعب صحية للأصحاء، لكن عندما يعتل الجسد، فإنها قد تصيب الرئة، وتسبب الالتهاب الرئوي، وقد تصيب الدم، وتتسبب في جروح بالجلد وفي بطانة المخ، متسببة في الالتهاب السحائي".وقالت صوفيا ديفيد، الباحثة في معهد سانغر، لـ"بي بي سي": "الأمر المثير للقلق، أننا شهدنا وفاة ألفي شخص عام 2015، لكن ما نخشاه أنه إذا لم يتخذ إجراء، فإن هذا العدد سيتزايد".وقفز عدد الذين توفوا بسبب بكتيريا كلبسييلا نيمونيا، المضادة لعقار كاربابينيم، من 341 شخصاً في أوروبا عام 2007 إلى 2094 شخصاً عام 2015.